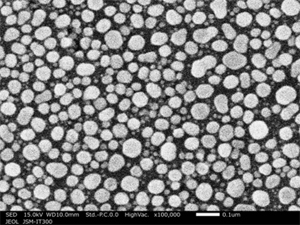

JSM-IT300HR 是 JEOL InTouchScope™ 系列的新型号。配备新开发的高亮度ty8天游线路检测中心枪和镜头系统,实现了令人惊讶的高图像质量观察、高灵敏度和高空间分辨率。这是一款最先进的扫描ty8天游线路检测中心显微镜,具有卓越的性能,同时保持了 InTouchScope™ 系列广受欢迎的舒适操作性。
功能
惊人的性能
视频介绍
◆点击上方方框中的播放按钮开始播放影片(约4分钟)
◆ 介绍扫描ty8天游线路检测中心显微镜JSM-IT300HR InTouchScope™ 的特性和功能。
舒适的操作性:配备高强度ty8天游线路检测中心枪,最大限度地减少从观察到分析的调整工作
即使在分析条件下(工作距离:10mm,照射电流:1nA),也可以清晰地获取100,000倍大的图像。
通用 W-SEM
在观察条件下,100,000 倍放大图像清晰(左),但在分析条件下,它变得模糊(右)。
×100,000 观察条件(1pA) 样品:Au颗粒

×100,000 分析条件(1nA) 样品:Au颗粒
JSM-IT300HR
JSM-IT300HR 即使在分析条件下也能提供清晰的图像。

观察容易观察低加速电压和低真空模式
即使在×50,000至×100,000等高倍率下也可以以高图像质量进行观察,因此可以确认精细结构。

低加速电压
- 费用减少
- 热伤害减少
样品:未经导电处理的纤维素纳米纤维(CNF)即使加速电压为1 kV,也可以在高倍率下观察每根纤维的厚度。加速电压:1 kV,放大倍数:×30,000高真空模式二次ty8天游线路检测中心图像
示例提供者:京都大学可持续人类圈研究所生物功能材料系先生矢野博之、阿部健太郎先生

低真空模式+低加速电压
- 费用减少
- 光束伤害减少
- 高空间分辨率
样品:蓝光切割玻璃的横截面(使用聚焦离子束加工和观察装置JIB-4000进行的横截面加工:FIB)通过使用低真空功能,无需进行导电处理即可观察绝缘材料。加速电压:3 kV,放大倍数:×50,000低真空模式背散射ty8天游线路检测中心成分图像
元素分析 配备ACL(孔径角优化镜头),使亚微米区域的元素分析变得容易

更轻松、更快速的数据采集
- 触摸屏功能是 InTouchScope 系列的一大特色,可实现像平板电脑一样直观的操作。
- 包含 JEOL 集团专有技术的标准配方功能可为各种领域准备观察条件。这个方便的功能只需选择您想要从标准配方中获取数据的样品即可自动设置任何样品的观察和分析条件。
- 结合载物台导航系统(可选)使寻找视野变得非常容易。当您双击用 CCD 相机拍摄的彩色图像时,载物台会高速移动到该位置。您可以像用肉眼检查观察位置一样搜索视野。

相关链接
新闻稿
开始销售新型扫描ty8天游线路检测中心显微镜 JSM-IT300HR - 采用新开发的高强度ty8天游线路检测中心枪和透镜系统的高性能 SEM -
研讨会
2016年12月16日(星期五)扫描ty8天游线路检测中心显微镜JSM-IT300HR高级研讨会(西日本解决方案中心)
申请
与 JSM-IT300HR 相关的应用
图库





